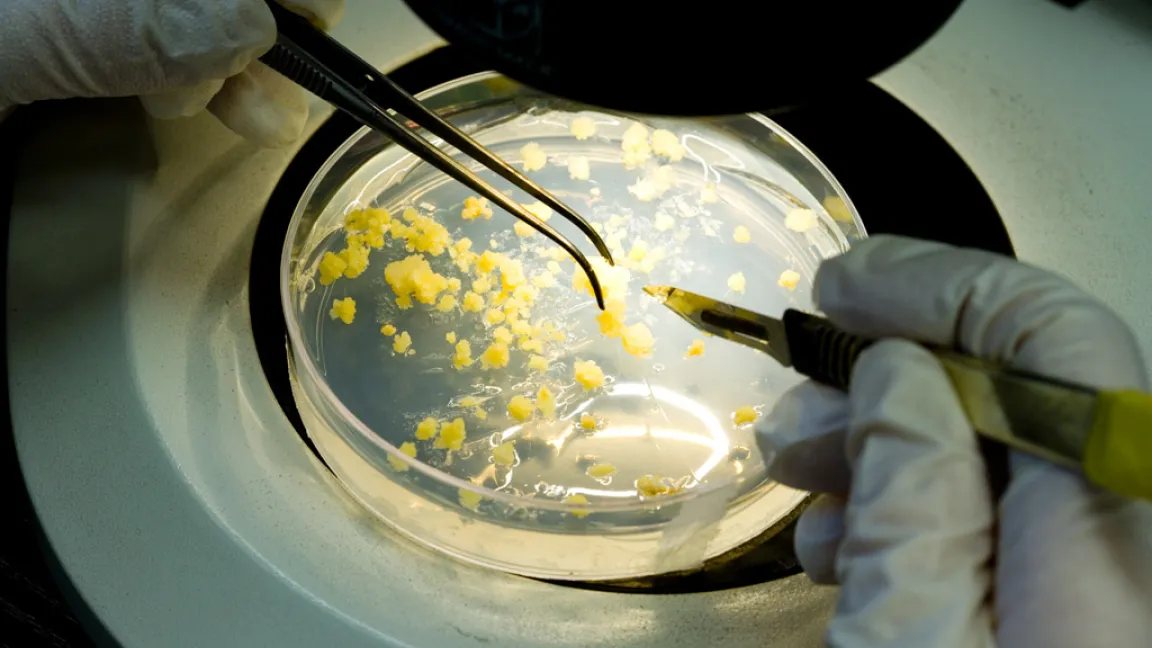

Bt-Mais hält Schädlinge fern – auch vom Nachbarfeld

Bt-Mais hält Schädlinge fern – auch vom Nachbarfeld
US-Studie bringt überraschende Vorteile ans Licht – Gentechnikauswirkungen genau untersucht
Der Anbau von gentechnisch verändertem Bt-Mais hat US-Farmern in den letzten Jahren mehrere Milliarden Dollar eingebracht. Überraschend: Besonders die Anbauer konventioneller Sorten profitierten von der effizienten Schädlingsbekämpfung durch den Bt-Mais. Zu diesem Ergebnis kam eine Studie von Professor Bill Hutchinson von der University of Minnesota.Bt-Mais gibt „Windschatten“
Hutchinson wertete für seine Studie das Aufkommen und die Auswirkungen des Maiszünslers im amerikanischen Corn Belt aus. In den Bundesstaaten Minnesota, Illinois, Iowa, Nebraska und Wisconsin wird seit 14 Jahren gentechnisch veränderter Mais gegen den wirtschaftlich bedeutendsten Maisschädling angebaut. Auf Flächen mit Bt-Mais ist der Schädling verschwunden. Die Pflanzen produzieren ein Toxin, das für den Maiszünsler tödlich ist. Doch auch auf den mit konventionellen Sorten bestellten Nachbarflächen ging das Zünslervorkommen erheblich zurück: um 28 bis 78 Prozent. Diese Flächen profitierten sozusagen vom „Windschatten“ der gentechnisch veränderten Sorten, also von der effizienten Schädlingsbekämpfung durch den Bt-Mais. Der Wissenschaftler hat den Nutzen in Zahlen gefasst. Demnach sparten die Farmer seit 1996 rund 6,8 Milliarden Dollar ein. Sie brauchten weniger Pflanzenschutzmittel und verzeichneten geringere Ertragsverluste. Zwei Drittel dieser Summe kam den Anbauern konventioneller Sorten zugute. Sie freuten sich zwar über dieselben Effekte wie ihre Kollegen mit Bt-Mais. Aber ihr Saatgut war um zehn bis zwanzig Dollar pro Hektar preiswerter. Unter dem Strich waren sie die Gewinner des Anbaus der genetisch veränderten Pflanzen.
Resistenzen vorbeugen
Damit die vorteilhafte Wirkung des Bt-Mais möglichst lange erhalten bleibt, gilt es Resistenzen des Maiszünslers gegenüber dem Bt-Toxin vorzubeugen. Dazu gehört es, gentechnisch veränderten Mais nicht flächendeckend anzubauen. Nach Vorgabe der amerikanischen Umweltbehörde (US-Environmental Protection Agency) müssen 20 bis 50 Prozent der Flächen mit konventionellem Saatgut bestellt werden. Damit verschafft man den Schädlingen Rückzugsgebiete. Auf diesen Refugien soll sich eine Bt-empfindliche Zünslerpopulation erhalten. Fallls Bt-resistente Zünsler entstehen, paaren sich diese mit den "normalen" Individuen aus den Refugien. Die Nachkommen sind nicht Bt-resistent, denn das neue Erbmerkmal wird nicht dominant vererbt.
Würde ausschließlich Bt-Mais angebaut, könnten einzelne resistente Schädlinge überleben und sich ohne störende Konkurrenz durch Artgenossen schnell vermehren. Momentan wächst Bt-Mais auf 63 Prozent der Gesamtanbaufläche der USA. Sollte dieser Anteil noch deutlich wachsen, so sind nach Hutchinson Sorgen um das langfristige Resistenzmanagement und die Nachhaltigkeit des gentechnisch veränderten Saatguts angebracht.
Unterschiedliche Erfahrungen
Der Wissenschaftler rechnet damit, dass ähnlich positive Effekte wie im Mais auch in anderen Bt-Kulturen auftreten können. Andere Forschungsergebnisse zeigen, dass die Auswirkungen von Bt-Pflanzen auch in eine andere Richtung gehen können. So zum Beispiel beim Anbau insektenresistenter Bt-Baumwolle in China. Hier wird von einer Zunahme schädlicher Weichwanzen berichtet, die von Natur aus immun gegenüber dem Bt-Toxin sind. Ein wirkungsvoller Schutz gegenüber den Wanzen und anderen Insekten ist also in diesem Fall nur durch die Kombination von Gentechnik und chemischem Pflanzenschutz möglich. Auch in Deutschland wurden in mehrjährigen Untersuchungen im Oderbruch die Auswirkungen von Bt-Mais auf die Fauna untersucht. Die Wissenschaftler des Julius Kühn-Instituts (damals Biologische Bundesanstalt) konnten keine eindeutigen Auswirkungen auf Vorkommen, Häufigkeit oder Entwicklung von Insekten und Spinnenarten feststellen. Wie groß die Vorteile der Grünen Gentechnik sind, ist also von Kultur und Standort abhängig.
Bt-Toxin auch im ökologischen Landbau
Das Gen, das Pflanzen unempfindlich gegenüber Insekten macht, stammt aus dem überall im Boden vorkommenden Bakterium Bacillus thuringiensis (Bt). Mit gentechnischen Verfahren konnte es mittlerweile in die Zellen verschiedener Pflanzenarten eingeschleust werden und veranlasst dort die Produktion eines Toxins, das wie ein Pflanzenschutzmittel wirkt. Nehmen Insekten das Gift auf, zerstört es deren Darmwand. Doch Bacillus Thuringiensis hatte bereits weit vor der Gentechnik eine Bedeutung im Pflanzenschutz. Seit 1964 sind Bt-Präparate in Deutschland als Pflanzenschutzmittel zugelassen. Sie bestehen aus Bakterien-Sporen und ihrem Toxin. Sie werden vor allem im Mais-, Kartoffel-, Gemüse- und Obstanbau eingesetzt und sind auch im ökologischen Anbau zugelassen.
Weitere Beiträge: